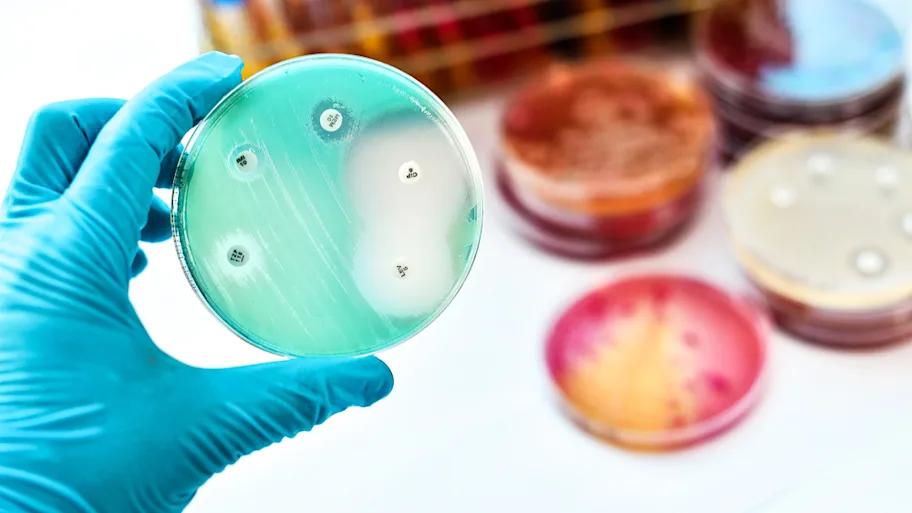

- Science News
- Life sciences
- Banknotes can transmit potentially antibiotic resistant strains of bacteria
Banknotes can transmit potentially antibiotic resistant strains of bacteria

Due to the global public health concern of antibiotic resistance, Dr Li and his team realized the importance of investigating how microbes are passed between humans and how antibiotic resistance can be spread around the world. Image by Shutterstock.
— Freya Wilson
If a commonly used item passed from person to person everyday around the world was found to carry potential harmful microbes, would you continue to use it? Dr Jun Li from the University of Hong Kong and his colleagues have been investigating the bacterial community present on banknotes, recently published in Frontiers in Microbiology.
Due to the global public health concern of antibiotic resistance, Dr Li and his team realized the importance of investigating how microbes are passed between humans and how antibiotic resistance can be spread around the world. To do this, bacteria were scraped from the surface of banknotes collected from hospitals and metro stations around Hong Kong in areas of varying population density and grown in the lab to determine the bacterial presence.
Despite doubt as to whether microbes can even survive on banknotes, the researchers found that the banknotes offer an environment that can, indeed, accommodate living bacteria. Over one third of the bacteria identified on the banknotes consisted of potentially pathogenic species. Widely recognized pathogens like Escherichia coli and Vibrio cholera were among these species, of which some strains can lead to death in infected people.
“In short, banknotes act as a medium ‘absorbing’ bacteria from other environments and the potential pathogens live quite well on the banknote surface,” said Dr Li.
Comparing the microbes found on banknotes with peoples’ hands, metro station air, drinking water and marine sediment, Dr Li and his team found that the banknotes harbour a much higher diversity of bacteria than that of the environmental samples.
When comparing the number of antibiotic-resistance genes between banknotes and the other environmental samples, Dr Li and his team found that the banknotes have a significantly higher abundance than the other samples. Of particular interest were clinically important antibiotic-resistance genes (those that are significant in the medical world) which were also higher in the banknotes.
“The high amount of antibiotic-resistance genes found from the banknotes is considerable and can potentially lead to the circulation of antibiotic resistance to humans and other environment,” suggests Li.
When evaluating the dissemination potential of the identified antibiotic-resistance genes, researchers found that the banknotes have a significantly higher potential than the environmental samples. Combining the clinically important antibiotic-resistance genes with the high dissemination potential suggests currency could possibly pose a health risk.
“The most important results are that banknotes harbour various bacteria that originate from different environments including human hands, dirt and water due to its frequent contact with human hands and the environment. We also found that banknotes contain much higher amounts of antibiotic-resistance genes and potential pathogens than other environmental samples, like water and marine sediment.”
Dr Li hopes that the findings of this study encourage a greater awareness of the potential risks in handling currency. “The most important recommendation we could raise is that before a cashless society develops, the banks and government should pay extra attention to the hygiene problem of the currency, which is still frequently used in our daily life. We recommend some routine disinfection of the currency from the bank, some public service ads reminding people to pay attention to wash the hands after touching currencies and the promotion of more electronic payment service, like mobile payment. We particularly would like to see the politicians and policy-makers inspired by this study.”